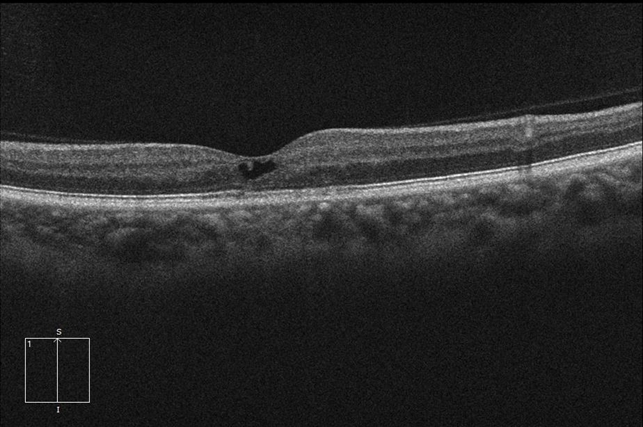
Macular telangectasia type 2 oct od Macular Telangectasia Type 2 OCT OD - Retina Image Bank

OCT angiography & macular telangiectasia Macular Telangectasia Type 2 OCT OD - Retina Image Bank, OCT angiography & macular telangiectasia
OCT Angiography & Macular Telangiectasia

Oct mactel telangiectasia angiography coats disease macular type. Oct macular type od file imagebank
Macular Telangectasia Type 2 OCT OD - Retina Image Bank
Oct macular type od file imagebank. Oct mactel telangiectasia angiography coats disease macular type
Oct macular type od file imagebank. Oct angiography & macular telangiectasia. Oct mactel telangiectasia angiography coats disease macular type
